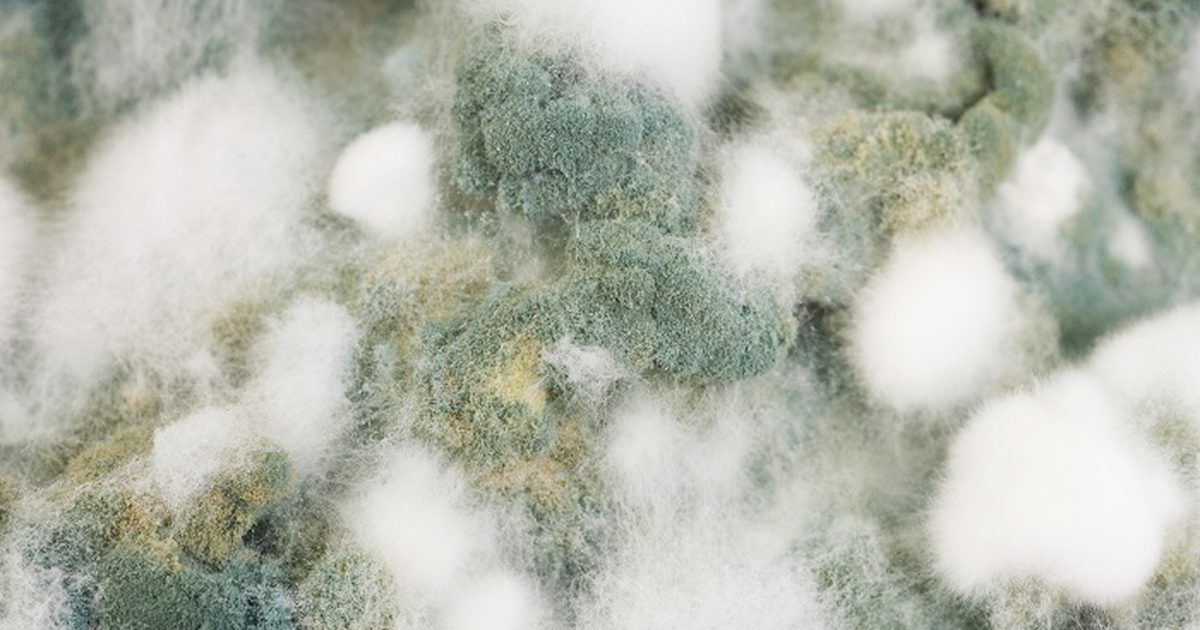

- Serving All Of Suffolk County for Over 10 Years -
Mold Removal Services - Hygienic Cleaning And Restoration
Dealing with mold damage in a home can be a challenging task, particularly when it comes to achieving long-lasting removal.
To ensure effective mold eradication, it is essential to rely on the expertise of a trained and fully certified technician.
Without professional intervention, there is a risk that the mold may not be completely eliminated,
leading to potential regrowth in just a matter of months.
Mold not only poses a threat to personal property but can also have a significant impact on the health of residents, particularly those with asthma or allergies. It is crucial to address mold issues promptly and thoroughly to safeguard the
well-being of everyone within the household.
By entrusting your mold removal needs to a qualified professional, you can have peace of mind knowing that the issue will be addressed comprehensively, minimizing the risk of recurring mold problems. Don't compromise on the health and safety of
your home and loved ones. Seek the assistance of a certified technician for effective and lasting mold removal.
- FREE Estimates 24/7
- Emergency 24 Hour 45 Minute Response Time
- Owner operated - personal service
- Always talk to a real person
- IICRC certified
- State of the art equipment
- Certified To Work With All Insurances
- Fully Licensed & Insured
Call: 631-595-0820
100% guarantee on all work
- BBB A+ rating
- Award-winning customer service
- 24/7 live calls
- Immediate response
- We bill directly to the insurance
- Free estimates
- Locally owned and operated
Call us straightaway, we give you peace of mind.
We are available 24 hours a day and 7 days a week. No matter what time it is, when you call us, we come to your rescue within the hour!
Here are some important facts about mold and mold remediation that you should be aware of:
- Rapid Growth: Mold has a remarkable ability to grow quickly. With just the presence of moisture, temperatures above 40 °F (4 °C), and organic materials, mold can start growing within 24-48 hours. It thrives in areas that lack sunlight, have limited airflow, and experience minimal disturbance.
- Property Value Impact: Mold can have a significant negative impact on the value of your home. Professional Builder Magazine highlights the detrimental effect of mold on property value. When mold is present, potential buyers may perceive it as a sign of poor maintenance and may be deterred from making an offer.
- Structural Damage: Mold not only affects the aesthetic appeal of your home but can also cause severe structural damage. Over time, mold can deteriorate building materials such as wood, drywall, and insulation, compromising their integrity and stability.
It's essential to address mold issues promptly and effectively to minimize the damage it can cause. Hiring professional mold remediation services is crucial for thorough mold removal and preventing its recurrence. Don't underestimate the potential consequences of mold growth in your home—take action to safeguard both the value and structural integrity of your property.
Simply cleaning visible mold is insufficient when it comes to effective mold remediation. Mold has the ability to grow in hidden places such as fiberglass insulation, ceiling tiles, ducts, behind drywall panels, within wall cavities, and behind wallpaper. Even for experts, distinguishing between mold, soot, and dirt without proper testing can be challenging. What you can see is just the tip of the iceberg, and a significant portion of mold growth may remain undetected.
Using bleach and detergent will not solve the mold problem entirely. While these cleaning agents may remove visible mold, if the sources of moisture and humidity are not addressed, the mold will regrow. Eliminating the root cause is crucial to prevent the recurrence of mold growth.
To ensure effective mold remediation, it is essential to enlist the help of professionals who have the expertise and tools to locate and eliminate hidden mold sources. By addressing the underlying moisture issues and implementing comprehensive remediation strategies, you can effectively eliminate mold and minimize the risk of its return.
Mold cleaning poses significant hazards that should not be taken lightly. Even a small number of mold spores, as few as 3-5, are enough to trigger allergic reactions in susceptible individuals. Some molds even produce mycotoxins, which can be carcinogenic or even deadly. Disturbing mold through vibrations or movement can cause the release of spores into the air, and it's startlingly easy to unintentionally dislodge hundreds of thousands of spores from a single patch of mold. This, however, is just the tip of the iceberg.
Recent research has shed light on the astounding prevalence of mold spores. In fact, up to one billion mold spores can be found in a mere square foot of drywall. This staggering number has a significant impact on air quality and poses risks to both property occupants and their health.
Given the potential dangers associated with mold and the astonishing abundance of mold spores, it is crucial to approach mold cleaning with caution. Seeking professional assistance from experts trained in mold remediation is recommended to minimize exposure risks and ensure thorough and effective mold removal. Safeguard your well-being and the air quality of your environment by entrusting the task of mold cleaning to qualified professionals.